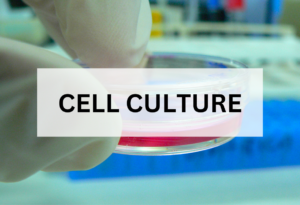
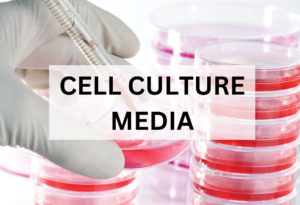

WELCOME TO LIFE SCIENCE
Cell culture or Tissue culture is the process by which cells are grown under controlled conditions.
Organoids are tiny, self-organized three-dimensional tissue cultures that are derived from stem cells.
Spheroids are three-dimensional (3D) cell aggregates that can mimic tissues and microtumors.
Multicellular tumour spheroids are three-dimensional structures composed of cancer cells.
Spheroid culture system is a revolutionary 3D cell culture system that is relatively low tech.
Glioblastoma is an aggressive type of cancer that can occur in the brain or spinal cord.
3D cell culture is a culture environment that allows cells to grow and interact with surrounding extracellular framework in 3D.
High-throughput screening is a method for scientific experimentation especially used in drug discovery.
Cells are the basic building blocks of all living things. The human body is composed of trillions of cells.
The cell culture media is often known as growth media, refers to any gel or liquid made to assist cellular growth in a laboratory setting.
3D bioprinting is an additive manufacturing process that uses organic and biological materials to combine and create artificial structures.
Immunology is a branch of medicine and biology that covers the medical study of immune systems in humans, animals and plants.
Stem cells are partially differentiated cells that can differentiate into various types of cells and proliferate indefinitely to produce more of the same stem cell.
Cryopreservation is a process that preserves organelles, cells, or any other biological constructs by cooling the samples to low temperatures.
Animal models are used to study the development and progression of diseases and to test new treatments before they are given to humans.